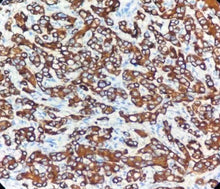
Charger l'image dans la galerie, CK 8 & 18 (DA047)

Cytokératine 8 & 18
Hôte : lapin
Localisation : Cytoplasme
Récupération de l’épitope par EDTA
Introduction :
CK18 est une kératine de type I, spécifiquement exprimée dans les épithéliums simples, glandulaires et transitionnels, mais absente des épithéliums stratifiés.
L’anticorps CK18 est hautement sensible pour les adénocarcinomes (tels que les adénocarcinomes gastro-intestinaux ou pulmonaires) et marque efficacement les tumeurs dérivées de l’épithélium simple ou glandulaire.
Il est à noter qu’une positivité peut également être observée dans certaines cellules tumorales de carcinomes épidermoïdes peu différenciés ; une interprétation intégrée avec d’autres marqueurs (tels que CK5/6) est donc nécessaire.
En tant que marqueur fondamental des tumeurs épithéliales, CK18 présente une valeur diagnostique majeure pour l’identification du site primaire des carcinomes métastatiques et la classification des carcinomes peu différenciés.
Contrôle positif : Tissu hépatique
| RMB1A064 | 3ml, 6ml, 10ml | Ready to use |